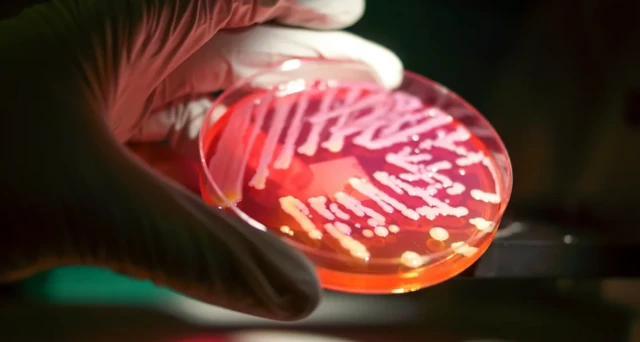
ባክቴርያ

በአንጀታችን ውስጥ ያሉ ባክቴሪያዎች ለአእምሯችን ጤና ጠቃሚ መሆናቸውን ያውቃሉ?

በአንጀታችን ውስጥ ያሉ ባክቴሪያ፣ ፈንጋይ እና ሌሎችም ጥቃቅን ነፍሳት (ኦርጋኒዝም) የተሻለ እንድናስብ ከማድረግ ባሻገር ለአእምሮ ጤና እንደሚረዱ ባለሙያዎች ይናገራሉ።
በአንጀት ውስጥ የተለያየ ዝርያ ያላቸው በትሪሊዮኖች የሚቆጠሩ ነፍሳት ይገኛሉ።
ባክቴሪያ፣ አርኬያ፣ ዩካርያ እና ሌሎችም ነፍሳት ከሰው ልጆች መፈጠር በፊት የነበሩ ሲሆኑ፣ በዝግመተ ለውጥ ተቀይረዋል።
በኮርክ ዩኒቨርስቲ ኮሌጅ የሚሠራው ጆን ክራይን እንደሚለው እነዚህ ነፍሳት በሰውነት ውስጥ ካሉ ሕዋሳት በቁጥር ይበልጣሉ። ሰዎች ሲፀዳዱ ከሰውነት ውስጥ እነዚህ ነፍሳት ይወገዳሉ።
'ማይክሮባክቴሪያ' በሚል የወል ስም የሚታወቁት ጥቃቅን ነፍሳት የሰው ልጆችን አካላዊ ጤና በመጠበቅ፣ በሽታን በመከላከል እና ምግብ እንዲብላላ በማስቻል ሚና ይጫወታሉ።
ሰውነት ማምረት የማይችለውን ጠቃሚ ንጥረ ነገርም ያመርታሉ።
የምናስብበት መንገድ የሚወሰነው በዘረ መል፣ በማንነት እና በማኅበረሰብም የሚወሰን ቢሆንም በሆዳችን ውስጥ ያሉ ባክቴሪያዎች ለአእምሮ ጤና ሚና እንዳላቸው ጥናቶች ያሳያሉ።
ድባቴ፣ ጭንቀት እና ሌሎችም የአእምሮ ህመሞችን በመከላከል ረገድ ያላቸው አስተዋጽኦም ቀላል እንዳልሆነ ጥናቶች ያመለክታሉ።
ለዚህ ጥናት መነሻው በአውሮፓውያኑ 1822 የነበረ ክስተት ነው። በወቅቱ አሌክሲስ ኤንት ማርቲን የተባለ ነጋዴ ማክኒክ ደሴት አቅራቢያ መንገድ ላይ ሲሸና አጠገቡ ጥይት ተተኮሰ።
አሌክሲስ የደረሰበት ጉዳት ከፍተኛ ከመሆኑ የተነሳ ሰውነቱ ውስጥ የነበረው ምግብ በአጠቃላይ ወጣ። ሊሞት ሲል ዊልያም ቤሞንት የተባለ ሐኪም ደረሰ።
ለአንድ ዓመት ያህል በተከታታይ ቀዶ ሕክምና በማድረግ ከጉዳቱ እንዲያገገም ጥረት አደረገ።
ሆኖም ግን ሆዱ ላይ ከደረሰው ጉዳት ማገገም አልቻለም። በተኩሱ የተፈጠረውን ቀዳዳ መድፈን አልተቻለም። በዚህ ቀዳዳ በኩል አንጀቱ ላይ ምርምር መደረግ ጀመረ።
ስለ ሰው ልጆች አንጀት የተሻለ ዕውቀት የተገኘው ከዚህ አጋጣሚ በኋላ መሆኑ ይነገራል።
የአሌክሲስ አንጀት ጤና ከስሜቱ ጋር የተያያዘ መሆኑን ሐኪሙ አወቀ።
ሐኪሙ የአንጀት ጤና "አባት" የሚባለውም ለዚህ ነው።
አእምሮ እና አንጀት አንዳቸው በሌላቸው ላይ ያላቸው ተጽዕኖ በዝርዝር መታወቅ ጀመረ።
በካሊፎርኒያ ዩኒቨርስቲ የምትሠራው ኤሌን አሲዮን እንደምትለው፣ በባህሪ እና በአንጀት ባክቴርያ መካከል ያለውን ትስስር የሚጠቁሙ ጥናቶች እየወጡ ነው።
እነዚህ ነፍሳት በአካላዊ ጤና ካላቸው ሚና ጎን ለጎን በአእምሮ ጤና ላይ ያላቸው ሚናም በጥናት እየታየ ነው።
ባለሙያዋ "ስለ አንጎል ስናስብ ከአንገት በላይ ያለውን ሰውነት በአጠቃላይ ነው የምናየው። ማይክሮቦች ከሰው ልጆች ቀድመው ይኖሩ እንደነበር ማስታወስ አለብን። ስለዚህም በዝግመተ ለውጥ ሒደት ውስጥ አብረን ነው እየተጓዝን ያለነው" ትላለች።
ምን ይሰማናል? እንዴት ያለ ባህሪ እናሳያለን? ለሚሉት ጥያቄዎች ምላሽ ለማግኘት የአንጀት ባክቴሪያን ማጥናት አስፈላጊ ነው።
ከሚጥል በሽታ እና ድባቴ ጋር በተያያዘ ለሚደረጉ ጥናቶች እንደ መነሻም ነው።
"ማይክሮቦች የአእምሮን ቅድመ ዕድገት እንደሚቆጣጠሩ ማወቅ ችለናል። ይህም በባህሪ ላይ ተጽዕኖ አለው። እንደ ሴሮቲን ያለ ንጥረ ነገር የሚመረተውን ከእነዚህ ነፍሳት ጋር በተያያዘ ነው" ስትል የጤና ባለሙያዋ ታስረዳለች።
አንጎላችን ከሰውነታችን ውስጣዊ ክፍል ጋር በሚያደርገው የመረጃ ልውውጥ ነው ስለእነዚህ ባክቴሪያዎች አስፈላጊነት ማወቅ የተቻለው።
የአንጀት ባክቴርያ ስሜትን የተሻለ በማድረግ እና ጭንቀትን በመቀነስ ረገድ ያላቸውን ሚና በአይጦች ላይ የተሠራ ጥናት ጠቁሟል።
በአይጦች ላይ የተሠራውን ጥናት መነሻ በማድረግ በሰዎች ላይ ባክቴሪያዎች የሚያመጡትን ለውጥ ለማወቅ ተችሏል።
ከባክቴሪያ ነጻ የሆኑ አይጦች ጭንቀት ተስተውሎባቸዋል። ከሌሎች አይጦች ጋር ለመቀላቀል ያሳዩት ፍላጎትም አነስተኛ ነው።
የሰው ልጆች ሰውነት ከአይጦች ሰውነት አሠራር በላይ እጅግ ውስብስብ ቢሆንም የጥናቱን ውጤት በሰው አካል ላይ ለመተግበር መነሻ ይሆናል።
ሁሉም ዓይነት ባክቴሪያ ጎጂ አይደለም። ሳይንስ ለሰው ልጆች ጠቃሚ የሆኑ ባክቴሪያዎችን መለየት ችሏል።

እነዚህ ሳይኮባዮቲክስ (psychobiotics) በመባል የሚታወቁ ጠቃሚ ባክቴሪያዎች በሰው አእምሮ እና አካል ላይ የሚያሳዩት ለውጥ ጉልህ ነው።
"ሁሉም ሰው ለአንድ ዓይነት ባክቴሪያ ተመሳሳይ ምላሽ ይሰጣል ማለት አይደለም" ስትል በካሊፎርኒያ ዩኒቨርስቲ የምትሠራው ኤሌን አሲዮን ትናገራለች።
የምግብ ለውጥ በማድረግ ሰውነት ውስጥ ያለውን ባክቴሪያ ዓይነት መለወጥ ይቻላል።
በኦክስፎርድ ዩኒቨርስቲ የሚሠራው ፕሮፌሰር ፊሊፕ በርንት እንደሚለው፣ የባክቴርያ መጠን ሲቀንስ የሚመጣ ህመምን ማስወገድ የሚቻለው አመጋገብን በማስተካከል ነው።
"በአንጀት ባክቴሪያ እና በሰው አንጎል መካከል ስለሚደረገው የመረጃ ልውውጥ የተሠራ ጥናት እንደሚጠቁመው የሰዎችን ስሜት በመለወጥ ረገድ ያላቸው ሚና ቀላል አይደለም" ይላል ባለሙያው።
ጠቃሚ ባክቴሪያን ማግኘት የሚቻልባቸው መንገዶች አሉ።
በአውሮፓውያን 2019 በተሠራ ጥናት መሠረት ሪታ ባይዎ የተባለች የሥነ ልቦና ባለሙያ እንዴት ጤናማ ባክቴሪያ ማምረት እንደሚቻል ግኝቷን ይፋ አድርጋለች።
ባክቴሪያ የሚያሳድግ መድኃኒት የተሰጣቸው ሰዎች 14 ዓይነት የባክቴሪያ ዝርያዎችን ማሳደግ ችለዋል።
ባሲለስ፣ ሰብቲለስ፣ ቢፍደምን ጨምሮ ሌሎችም ባክቴሪያዎችን በአራት ሳምንታት ውስጥ አሳድገዋል።
ባክቴሪያ የሚያሳድግ መድኃኒት ያልወሰዱ ሰዎች የስሜት መዋዠቅ አሳይተዋል።
በዚህ ጥናት በአጠቃላይ የተሳተፉት 71 ሰዎች ናቸው። ድባቴ እና ጭንቀት ያለባቸው ሰዎችን ጨምሮ የአንጀት ባክቴሪያ መኖር እንዴት ለውጥ ሊያመጣ እንደሚችል ለማወቅ ተችሏል።
የፎቶው ባለመብት, Getty Images
የጥናቱ ተሳታፊ ባለሙያ እንደሚለው፣ ሁሉም ሰው በባክቴሪያ በአንጀት ውስጥ መኖር ምክንያት ደስተኛ ይሆናል ወደሚል ድምዳሜ መሄድ አይቻልም።
ለአእምሮ ጤና የሚረዱ መድኃኒቶችን የሚተካ ግኝትም አይደለም።
ሆኖም ግን ጤናማ ባክቴሪያዎች ያላቸው ሚና ከፍተኛ እንደሆነ በጥናቶቹ አማካይነት ለማወቅ ተችሏል።
"የአንጀት ባክቴሪያ መጠን መለዋወጥ የስሜት መለዋወጥ ሊያመጣ እንደሚችል ጥናቶች ቢጠቁሙም እንደ ስሜት መዋዠቅ ብቸኛ ምክንያት አይወሰዱም። አመጋገብን በማስተካከል ጤናን ማስተካከል እንደሚቻል ግን መረዳት እንችላለን" ሲል ባለሙያው ያስጠነቅቃል።
"ብዙ ሰዎች ጤናቸውን ለመጠበቅ በሚል በጥናቱ ላይ ያላቸውን ፍላጎት ገልጸዋል። ከኮቪድ-19 ወረርሽኝ ወዲህ ያለውን የድባቴ እና ጭንቀት ቁጥር መጨምር ከግምት ውስጥ ማስገባትም አለብን" ሲል በጥናቱ የተሳተፈው ባለሙያ ይናገራል።
ሌላኛው አጥኚ ቺንግ ካዎ እንደሚለው የአእምሮን ጤና ለማስጠበቅ የአንጀት ባክቴሪያ መኖር ያለውን ሚና በጥናት ማረጋገጥ ተችሏል።
ጥናቱ ሲካሄድ ባክቴሪያ የተሰጣቸው ሰዎች በሽታ የመከላከል አቅማቸው ጨምሮ ተገኝቷል።
የአንጀት ባክቴሪያ ከአእምሮ የማሰላሰል እና ድርጊት ከመከወን ብቃትም ጋር ይተሳሰራል።
በዩናይትድ ኪንግደም 14,542 ሴት ነርሶች ላይ በተሠራ ጥናት የአንጀት ባክቴሪያ ከአእምሮ ብቃት ጋር ያለውን ትስስር ማወቅ ተችሏል።
የባክቴሪያ በአንጀት ውስጥ መኖር ብቻ ሳይሆን የተለያየ ዓይነት ባክቴሪያ አንጀት ውስጥ መኖር ያለው ሚናም በጥናት ታውቋል።
"ውስብስብ ጉዳይ ስለሆነ ተጨማሪ ጥናቶች ማስፈለጋቸው የግድ ነው። እንዴት ባክቴሪያ እንደሚሠራ መገንዘብ እንድንችል ጥናቶች በብዛት መሠራት አለባቸው።
ባለሙያው እንደሚለው፣ ባክቴሪያ ለአካል እና ለአእምሮ ጤና የሚኖውን ሚና መረዳት አስፈላጊ ቢሆንም ጤናማ ሕይወትን ለመምራት በዋናነት የፋይበር መጠናቸው ከፍ ያሉ ምግቦችን እንዲሁም አትክልት እና ፍራፍሬ ማዘውተር ይመከራል።











